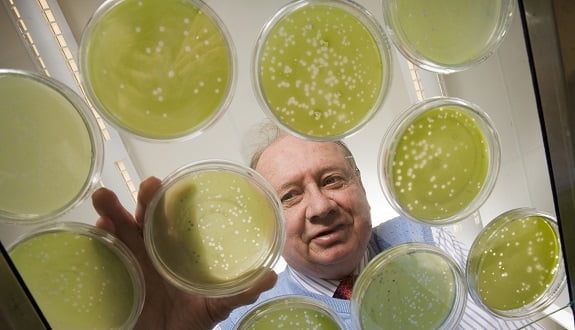
Van Etten

Amerika’da Johns Hopkins ve Nebraska Üniversitesinde yapılan bir araştırmaya göre, yosun virüsü kavrama yeteneğinizi etkiliyor.
Hiçbir şeyi doğru yapamadığınız günleriniz olmuyor mu?
Bazı günler aynaya bakıp “ben bunu neden yaptım ki?” dediğiniz zamanlar olmuyor mu?
Belki de aslında gerçekten aptal değilsiniz. Belki de, kavrama yeteneğinizi etkileyen yosun virüsünden etkilenmiş olabilirsiniz.
Amerikada Ulusal Bilim Akademisi tarafından yayınlanan çalışmada, “Kloro virüs ATCV-1, insan orofarenks viromunun bir parçasıdır ve insanlar ile farelerde bilişsel işlevlerde değişikliklerle ilişkilidir.” deniliyor.
Johns Hopkins ve Nebraska Üniversitesindeki büyük bir grup bilim adamı, mukoza yüzeylerimizi dolduran mikroorganizmaları inceledi. Bunun sonucunda beklenmedik bir şekilde yosundan gelen ATCV-1 virüsünü keşfettiler. Daha önceleri insanların bu virüsten etkilenmediği düşünülüyordu. Ama 92 kişinin boğazlarından alınan örnekler incelendiğinde 40 kişide bu virüsün bulunduğu gözlendi.
Raporda “ATCV-1 DNA‘nın varlığı demografik değişkenler ile ilişkili değildi. Ama görsel işleme ve görsel motor hızı ile bilişsel değerlendirmeler performansında, mütevazı ama istatistiksel olarak anlamlı bir azalma ile ilişkili bulunmuştur.” yazıyor.
Bilim adamları, aynı virüsü test etmek için deney farelerine enjekte ettiklerini ve aynı sonuçla karşılaştıklarını da belirttiler.
Bilim adamları, bu virüsün göllerde ve nehirlerde bulunan yeşil alglerde bulunduğunu ve bu virüsü keşfettiklerinde ilk olarak bunun ne olduğunu anlamadıklarını söylediler.
Nebraska Üniversitesinde Profesör James L. Van Etten’ın söylediğine göre” Bu virüsün bulaşıcı olduğuna dair bir bulgu henüz yok. En iyi tahminim bu virüs, şu anda araştırmakta olduğumuz başka mikroorganizmalarla boğaz yoluyla bulaşabilir.”
Belki bu virüs bazı insan davranışlarını açıklamaya yardımcı olabilir. Mesela virüsü kaptıktan sonra terfi almak üzereyken işinizi, eşinizi ya da evinizin yolunu kaybetmeniz bunlara basit bir örnek olabilir.
Cem Yılmaz’ın Filmi “Pek Yakında” Sosyal Medyada Sınıfı Geçti